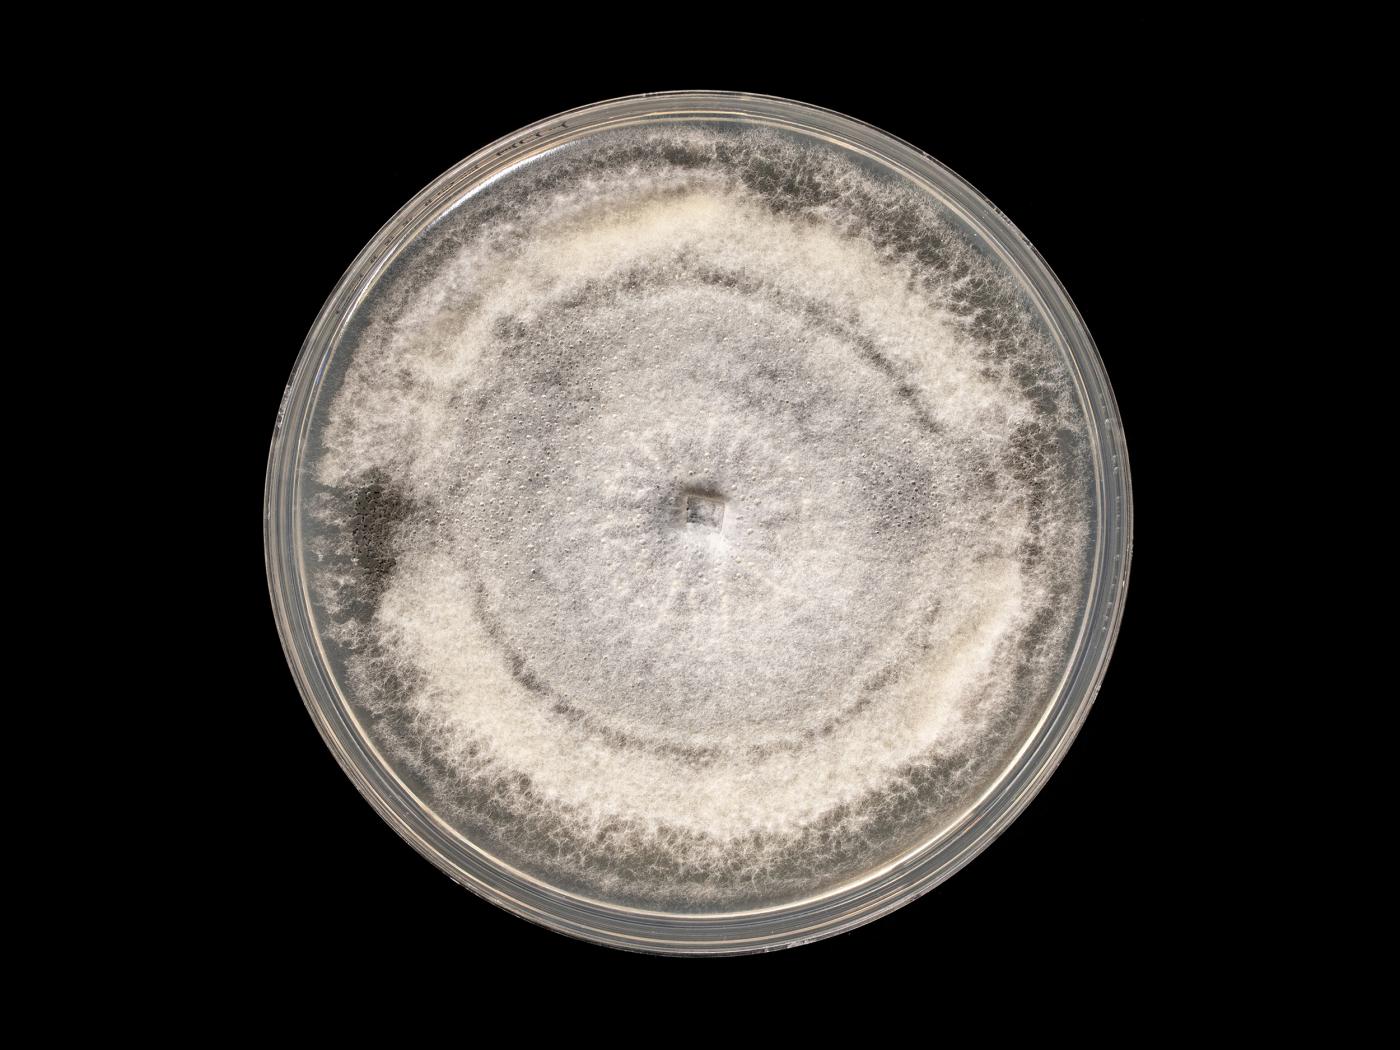

Nom latin :
Colletotrichum coccodes
Nom latin synonyme :
Chaetomium coccodes, Colletotrichum atramentarium
Morphologie
- Fructification : Acervule globuleux, brun-noir avec setae brun foncé. Diamètre : 150-300 µm.
- Conidies : Cylindriques à fusiformes. Hyalines. Sans septation (= amérospores). Petites guttules souvent localisées aux extrémités. Lorsque regroupées en masse (exsudat conidien), les conidies ont une teinte hyaline à orange saumon. Dimension : 16-24 x 2,5-4,5 µm.
- Cellules conidiogènes : Conidiophores phialidiques, sans septation (= unicellulaires), cylindriques et hyalins. Dimension : 30-45 x 6-7 µm.
- Microsclérotes : Abondants sur milieu de culture et sur la plante hôte. Grisâtres (= jeunes sclérotes) / noirs avec des setae bruns (= sclérotes matures). Les microsclérotes peuvent se transformer en acervules. Diamètre : 110-160 µm.
- Appressoria : Couleur cannelle. Ovoïdes ou claviformes à ellipsoïdes; parfois de forme irrégulière et lobés. Dimension : 5-14 x 4-11 µm. Visibles en dessous des mises en culture.
Ne pas confondre
La forme des conidies de C. coccode, C. acutatum et C. gloeosporioides peuvent se ressembler.
Informations complémentaires
Colletotrichum coccodes est souvent phytopathogène chez les Solanacées. (Les deux maladies les plus communes sont la dartrose de la pomme de terre et l'anthracnose de la tomate.)
Dommages
Le champignon Colletotrichum coccodes peut affecter les cultures suivantes : piment, poivron, pomme de terre, potiron et tomate.
Cultures ou autres organismes affectés
Pomme de terre
/fr/maladies-parasitaires/champignons/colletotrichum-coccodes/pomme-de-terre-dartrose
Pomme de terre - Dartrose (Colletotrichum coccodes)_1
Pomme de terre - Dartrose (Colletotrichum coccodes)_2
Pomme de terre - Dartrose (Colletotrichum coccodes)_3
Pomme de terre - Dartrose (Colletotrichum coccodes)_4
Pomme de terre - Dartrose (Colletotrichum coccodes)_5
Pomme de terre - Dartrose (Colletotrichum coccodes)_2
Pomme de terre - Dartrose (Colletotrichum coccodes)_3
Pomme de terre - Dartrose (Colletotrichum coccodes)_4
Pomme de terre - Dartrose (Colletotrichum coccodes)_5
Tomate
/fr/maladies-parasitaires/champignons/colletotrichum-coccodes/tomate-anthracnose
Tomate - Anthracnose (Colletotrichum coccodes)_1
Tomate - Anthracnose (Colletotrichum coccodes)_2
Tomate - Anthracnose (Colletotrichum coccodes)_3
Tomate - Anthracnose (Colletotrichum coccodes)_2
Tomate - Anthracnose (Colletotrichum coccodes)_3